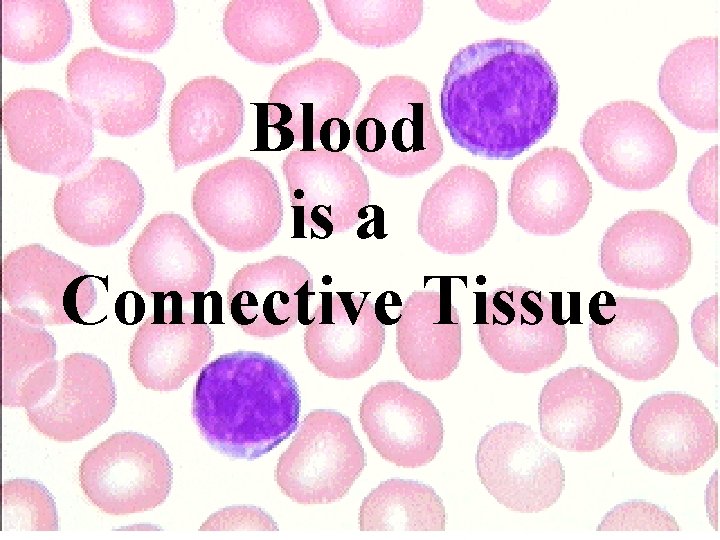
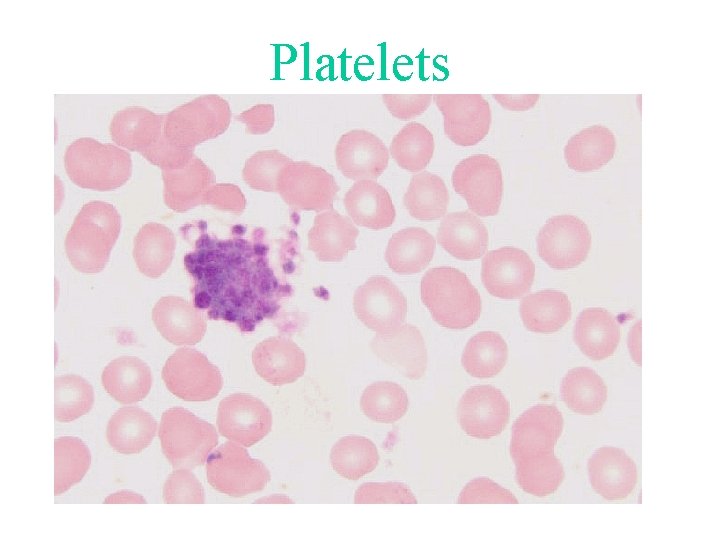

Blood Blood is a Connective Tissue The Cells

Blood
Blood is a Connective Tissue

The Cells of Blood are Called “Formed Elements” Agranulocytes Monocytes Lymphocytes Granulocytes Neutrophils Acidophils Basophils Cells divide and differentiate. Terminally differentiated. Erythrocytes No organelles . Platelets Cell fragments .

The Hematocrit. Left: Tubes with blood before centrifugation. Right: After centrifugation. The erythrocytes represent 43% of the blood volume in the centrifuged tube. Between the sedimented erythrocytes and the supernatant light-colored plasma is a thin layer of leukocytes called the buffy coat.

The Erythrocyte or Red Blood Cell

Erythrocytes 99. 5% of the formed elements of blood. Biconcave disks 7. 5 u in diameter. Lack cell nucleus, other organelles, RNA. Have a specialized cell membrane Have enzymes to produce ATP and NADPH Circulate for 120 days.

The Leukocytes or white blood cells Granulocytes Neutrophils Acidophils Basophils Agranulocytes Monocytes Lymphocytes

Neutrophils 60% of leukocytes Multilobed nucleus Very small specific granules Phagocyte for bacteria

3 Days 4 Days 6 -7 Hours CONNECTIVE TISSUE 1 -4 Days

“Band Cell”

Acidophil = Eosinophil ~5% of Leukocytes Bi-lobed nucleus Large granules (~1 um) Functions in allergies and worm infections

Basophils < 1% of leukocytes Elongated S-shaped nuclei Large heterogeneous, basophilic granules Secrete histamine and heparin

Monocytes 5% of leukocytes Pale irregular nucleus Largest of the leukocytes Precursors to macrophages Not phagocytic in blood

Main Functions of Macrophages 1. Ingest bacteria and cellular debris 2. Secrete various chemical messengers 3. Coordinate cell activities in inflammation and wound healing 4. Remove aged red blood cells 5. Roles in antibody formation

Diversity of Macrophages

The Mononuclear Phagocyte System MPS Includes monocytes and all cells that come from them. Examples: histiocytes of C. T. Kupffer cells of liver microglia of brain alveolar macrophages Excludes unrelated phagocytic cells that do not come from monocytes. Examples: neutrophils, Sertoli cells, mesangeal cells

Tweedledee told Alice in through the looking glass Contrariwise if it was so it might be and if it were so it would be. But as it isn’t it ain’t. That’s logic. …. and that’s the reticuloendothelial system.

Lymphocytes Small Medium Large constitute about 30% of leukocytes. have a small dense round nucleus and a small rim of cytoplasm. can divide and differentiate.
Platelets

Platelet

Cytological Structures in Platelets Structural components microtubules, actin, myosin Granules alpha, delta, lambda Membranes systems plasmalema, open canalicular system, dense tubular system

Functions of Platelets Primary aggregation Secondary aggregation Blood coagulation Clot retraction Clot removal

All Done
- Slides: 23